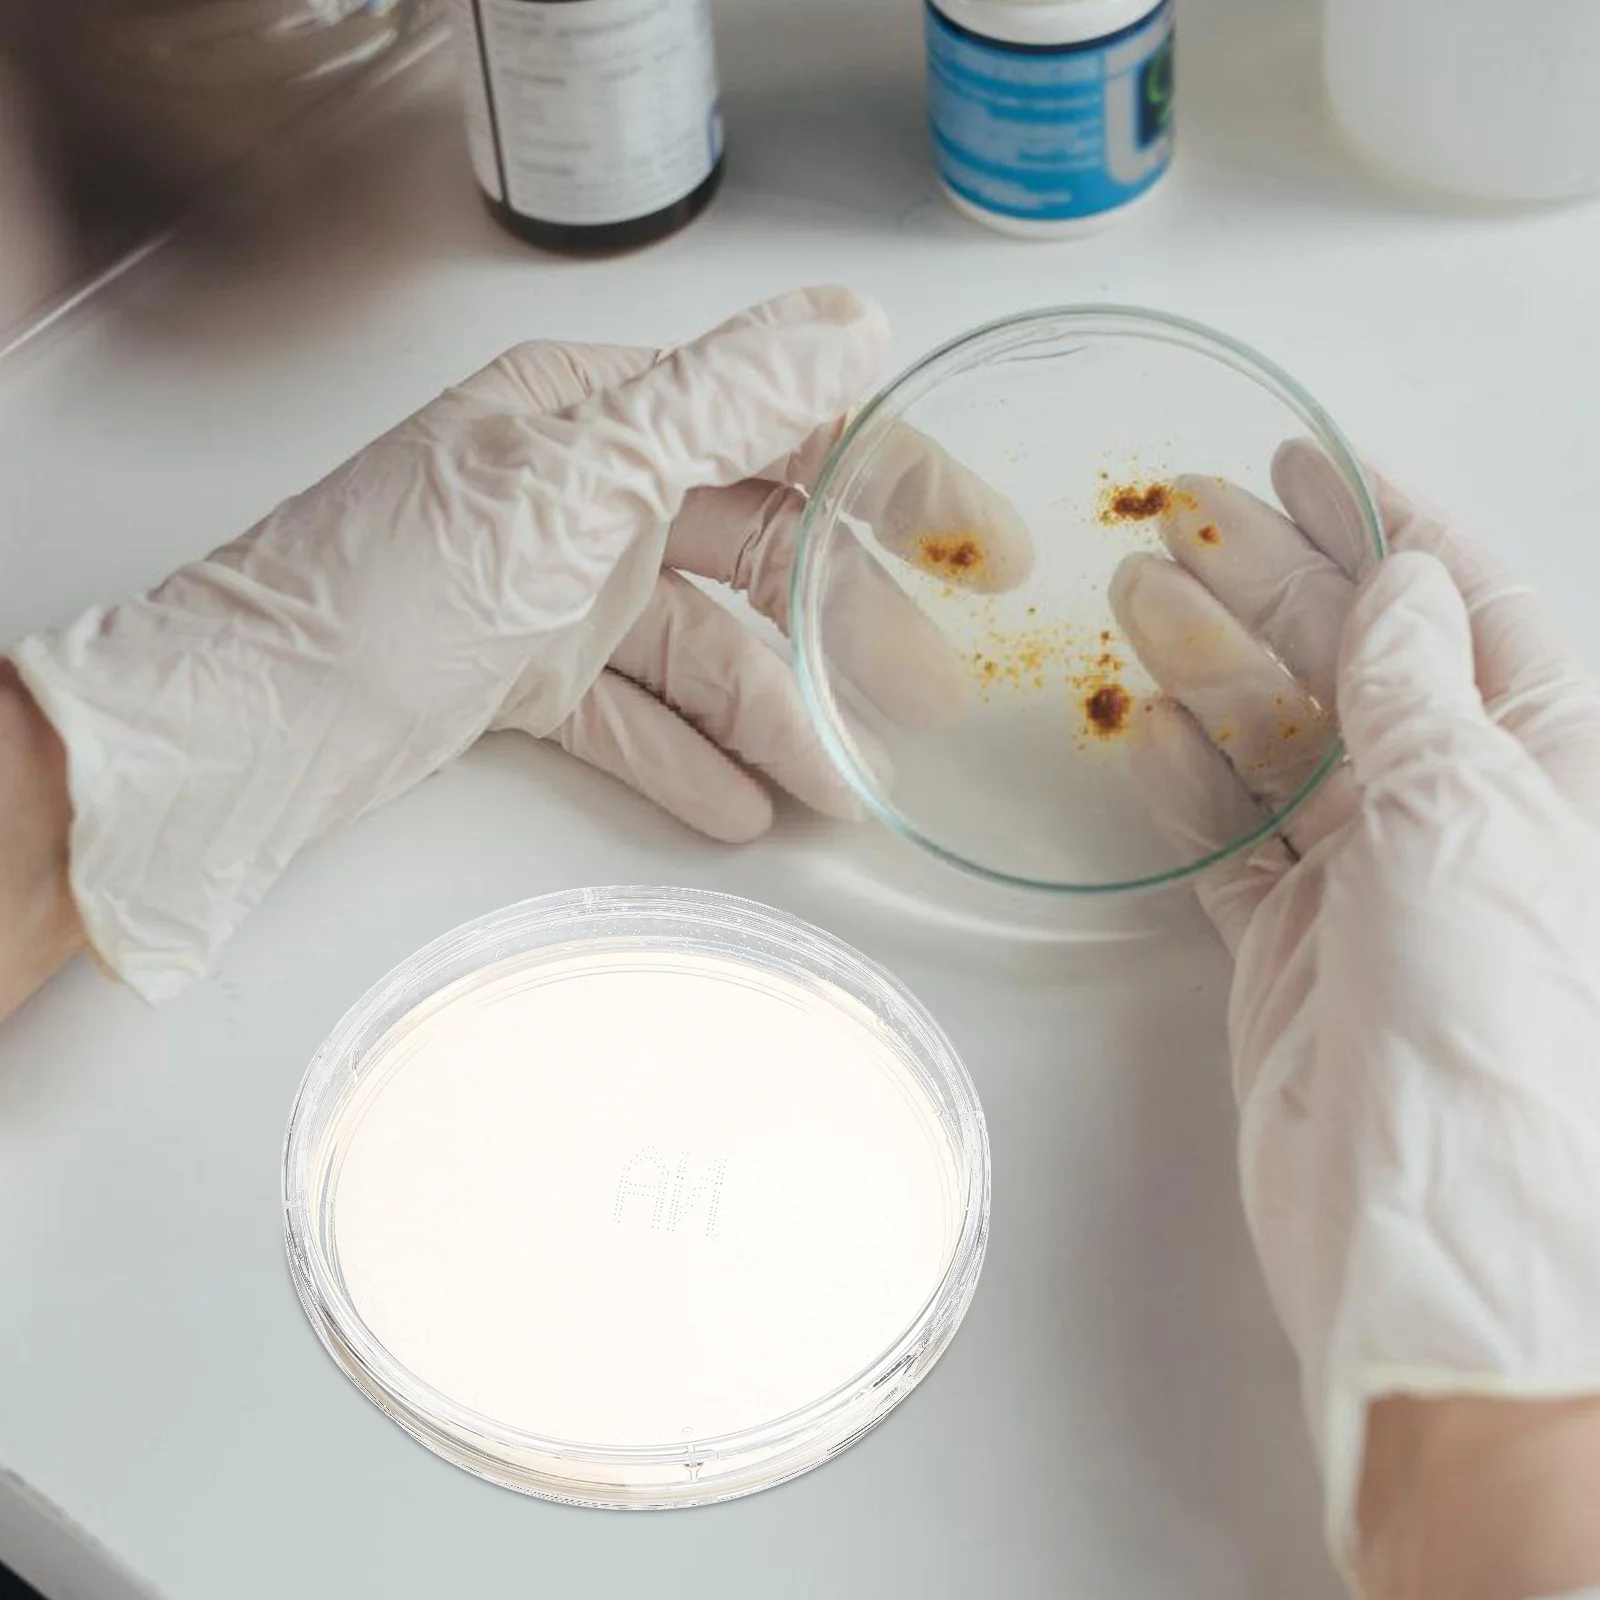
10Pcs Agar Plates Portable Prepoured Petri Plates for Laboratory Science Project Experiment Supplies Lab Agar Plate

Складная корзина для белья из нетканого материала, большая вместимость с ручкой, органайзер для грязной одежды, экономия места
Графік зміни ціни & курс обміну валют
Користувачі також переглядали

$14.04
Милые маленькие животные цветочный узор диванная подушка чехол милая птица ежик олень лебедь кролик подушка чехол 30x30cm бежевый
joom.ru
$19.26
Vintage Hair Clips for Women Acetate Hair Claw Elegant Colorful Hollow Out 5cm Hair Clip Girls Hair Accessories Claw Clip New
joom.ru
$108.64
Минималистичная люстра в скандинавском стиле для столовой Wabi Sabi, осветительные приборы для спальни
aliexpress.ru
$16.63
1 пара, клыки переднего бампера для BMW 3-Series F30 F31 2012 2013 2015 2014 2016 2017 2018
aliexpress.ru
$10.94
Fire and Ice Art Flannel Blankets Godfather Blankets Bed Couch Sofa Lightweight Travelling Camping Bedspread Printed Throw
aliexpress.ru
$2.36
Cute Bear Rabbit Phone Case For Xiaomi Redmi Note11 11E 11S 10 10A 10X 10S 9C 9 8 7 Pro Plus 10C 9A 9Prime 4G 5G Cover
aliexpress.ru
$1.97
Phone Case for OPPO A57S A54 A74 A94 A54S A53S A53 A52 A9 A5 A15 A16 A17 A91 A96 A76 Battery Motherboard Circuit board Case
aliexpress.ru
$3.05
Fashion Creative Acrylic Jewelry Dazzling Color Mardi Gras Festival Carnival Gifts Woman's Statement Pendant Dangle Earrings
aliexpress.ru
$9.90
Bowls Bowl Ceramic Soup Pasta Serving Cartoon Japanese Cereal Rice Salad Porcelain Dessert Kids Breakfast Dish Snack Style Child
aliexpress.ru
$22.13
Новинка 2023, Смарт-часы с ЭКГ + ППГ, Bluetooth, звонки, мужской музыкальный плеер, водонепроницаемый спортивный фитнес-трекер, Смарт-часы с ремешком из нержавеющей стали
aliexpress.ru
$0.85
Watch Strap Smart Watch Multicolor Silicone Watch Band 14mm With Installation Tool Replaceable Strap For Garmin Lily
aliexpress.ru
$1.69
10 шт. Защитная крышка для наконечника кухонного ножа, крышка для наконечника ножа, практичная пластиковая защитная крышка для ножа
aliexpress.ru
$36.18
Детский конструктор «Неистовый зоопарк», подарок мужчинам и женщинам на день рождения
aliexpress.ru
$60.69
Женская мода Новые шорты для плавания Черные кружевные шорты для плавания United Bikini Bottom M
joom.ru
$98.31
PSA Коврик автомобильный 2 и 3 ряда L3 Peugeot TravellerCitroen Spacetourer PSA DK00000027
goods.ru
$482.70
Матрас ортопедический Доктор Бобырь C4 S1200 Roll 120х190 26 см, Белый, C4 S1200 Roll
goods.ru
$51.89
women's sweaters early autumn european american fashion casual long-sleeve knitwear slim fit all-match solid color bottoming sweater to, White;black
dhgate.com
$1.12
3D DIY Christmas Series Silicone Sugar Baking Decoration Christmas Baking Tools Chocolate Hand Kitchen Tools Biscuits Tree B5Z4
aliexpress.com
$55.97
Lámpara de pared ARRIBA ABAJO proyector baño habitación húmeda iluminación lámpara de vidrio opal Globo 7816
manomano.es
$59.31
storage boxes & bins elastic plain solid sofa cover stretch tight wrap all-inclusive for living room funda couch armchair
dhgate.com
$29.72
plus ultra become a hero gym anime cartoon logo men's black t-shirt size s - 3xl loose size tee shirt sport hooded sweatshirt hoodie
dhgate.com
$3.43
Массажная палочка-ролик, прочный удобный массажер для шеи, спины, ног, ручной инструмент для релаксации мышц, массажный ролик
aliexpress.ru
$15.82
10Pcs Agar Plates Portable Prepoured Petri Plates for Laboratory Science Project Experiment Supplies Lab Agar Plate
aliexpress.ru
$7.99
Round Bamboo Woven Tea Basket Mini Storage Basket Lid Dustproof Practical Desk Organizer Small Bamboo Woven Garbage Bin
aliexpress.ru
$11.72
OSRS Style cover (Old School Runescape) T-Shirt funny t shirts man t shirt man plain anime t shirts oversize T-Shirt
aliexpress.ru














